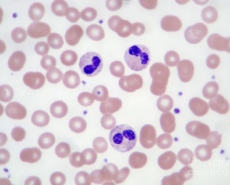

ПЕРЕЧЕНЬ
ПЛАТНЫХ УСЛУГ ДЛЯ ИНОСТРАННЫХ ГРАЖДАН
оказываемых в УЗ «Гродненская областная инфекционная клиническая больница
по желанию иностранных граждан с учетом стоимости
расходных материалов и изделий медицинского назначения
-
Лабораторные исследования
-
Ультразвуковая диагностика
-
Рентгеновская компьютерная томография
-
Рентгенологические исследования
-
Функциональная диагностика
-
Эндоскопическое исследование
-
Анестезиология
-
Консультации врача-инфекциониста(педиатра)
-
Пребывание в палатах
-
Массаж
-
Вакцинация
-
Диагностика вирусных гепатитов